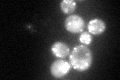
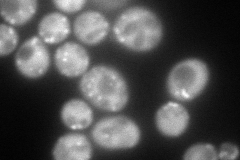
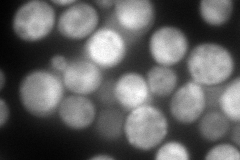
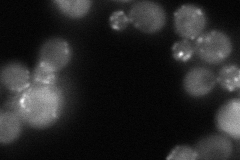
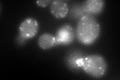

View description
Actin cortical patch component, interacts with the actin depolymerizing factor cofilin; required to restrict cofilin localization to cortical patches; contains WD repeats
Localization:
Intensity:
Fold change:
Significance:
-
C’ GFP library in SD
punctate, cytosol99.57 -
N' NOP1pr-GFP in SD
cytosol,punctate217.041 -
N' TEF2pr-mCherry in SD
punctate248.375 -
N' NATIVEpr-GFP in SD
punctate,bud neck78.0084 -
N' TEF2pr-VC and Cyto-VN in SD

#N/A0 -
C’ GFP library in SD+DTT
punctate, cytosol188.951.89Yes -
C’ GFP library in SD+H2O2

punctate, cytosol135.011.35Yes -
C’ GFP library in Starvation Media

punctate, cytosol171.81.72Yes -
C’ GFP library on the background of Pup2-DaMP

vacuole -
C’ GFP library on the background of CCT mutant

punctate, cytosol123.1761.237No
